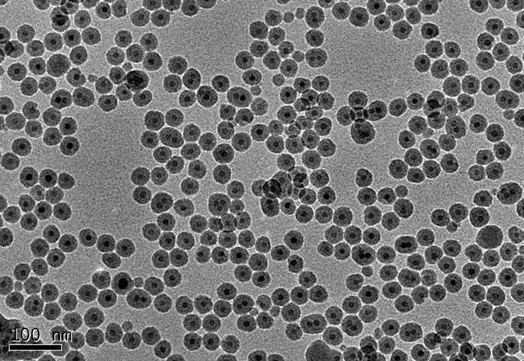
油酸修饰的四氧化三铁磁性纳米颗粒（高温热解法） Ferromagnetic nanoparticles

油酸修饰的四氧化三铁磁性纳米颗粒(高温热解法) Ferromagnetic nanoparticles
发布时间:2023-02-07     作者:zhn   分享到:
基本信息
产品名称 油酸修饰的四氧化三铁磁性纳米颗粒(高温热解法)
英文名称 Ferromagnetic nanoparticles
别名 油酸修饰的四氧化三铁磁性纳米颗粒(高温热解法)
英文别名 Ferromagnetic nanoparticles
规格或纯度 铁浓度:1 mg/mL
运输条件 冰袋运输
一般描述
油酸修饰的四氧化三铁磁性纳米颗粒(高温热解法):油溶性,可分散在环己烷、氯仿、四氢呋喃等溶剂中1、 磁性药物载体构建 2、 磁流体、磁性油墨等制备 3、高温热解法制备的粒子磁性更强、尺寸更均一
相关属性
储存温度 2-8°C储存
用途:
荧光免疫分析
酶免疫分析(EIA)
荧光显微镜
共焦荧光显微镜
流式细胞术/图像细胞术
磁细胞分离
磁性粒子
微流体
其他研究和工业应用
相关产品:
定制各种上转换纳米颗粒
油溶性核壳结构上转换纳米颗粒
无表面基团水溶性上转换纳米颗粒
氨基修饰上转换纳米颗粒
羧基修饰上转换纳米颗粒
叠氮修饰上转换纳米颗粒
PEG包裹上转化纳米颗粒
PEG-NH2修饰上转换纳米颗粒
PEG-COOH修饰上转换纳米颗粒
DSPE-PEG修饰上转换纳米颗粒
MAL-PEG修饰上转换纳米颗粒
聚丙烯酸修饰上转换纳米颗粒
聚苯乙烯修饰上转换纳米颗粒
致密二氧化硅包覆上转换纳米颗粒
介孔二氧化硅包覆上转换纳米颗粒




齐岳微信公众号
官方微信
库存查询